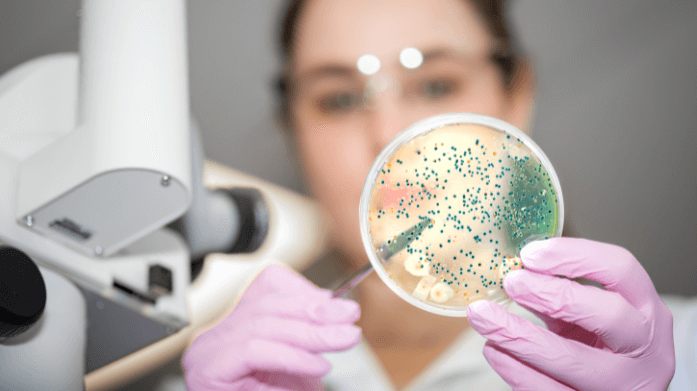

Simți că venirea primăverii te îmbie la schimbări verzi în farfurie, cu mai multe fructe și legume? Dacă deja ți-ai ascultat corpul, gândește-te pentru o secundă ce îmbunătățiri ai observat de când ai schimbat compoziția propriei farfurii.
Simplist, îți spunem doar că, instinctiv, ai acționat benefic în favoarea echilibrării microbiomului intestinal, și implicit efectele au devenit vizibile pe multiple paliere ale organismului tău.
Însă microbiomul intestinal, cu toate posibilele dezechilibre, înseamnă o poveste despre armonia fizică și mentală, care merită înțeleasă de toată lumea.
Rămâi alături de noi și descoperă toate substraturile poveștii despre microbiomul intestinal și cum să-l menții sănătos!
Ce înseamnă microbiomul uman, dar microbiota?
Pentru o înțelegere de ansamblu, povestea noastră trebuie să înceapă de la nivel macro. Încă din secolul al XVII-lea, lumea medicală și-a manifestat interesul pentru rolul pe care microbiomul îl joacă în susținerea sănătății organismului, însă abia în prezent, acest domeniu este aprofundat, pe fondul înregistrării a numeroase progrese în înțelegerea ADN/ARN și a dezvoltării tehnicilor moderne de calcul.
Astăzi știm cu precizie că termenii de microbiom și microbiotă nu sunt sinonimi și desemnează aspecte diferite ce țin de corpul uman.
Pe scurt, microbiota reprezintă totalitatea microorganismelor, de la bacterii, virusuri sau fungi, care trăiesc într-un anumit loc din corp, cum ar fi intestinul. Pe de altă parte, microbiomul se referă la întreaga „colecție” de microbiote din tot corpul nostru.
Microbiomul este ca o zonă-tampon între corpul nostru și lumea exterioară. Iar bacteriile care îl populează pot avea un impact semnificativ asupra sănătății, fiind implicate în majoritatea proceselor din corp, inclusiv la fortificarea sistemul imunitar.
Nu pierde din vedere că în corpul uman trăiesc peste 1.000 de tipuri de microorganisme, adunate în trilioane de celule minuscule care colaborează cu celulele noastre. Fiecare zonă a corpului găzduiește un tip specific de microbiotă: intestinul, cavitatea bucală, pielea, tractul respirator sau zona intimă.
Foarte important! Microbiomul se schimbă constant în funcție de regimul alimentar pe care îl urmăm, de mediul în care trăim sau de medicamentele/suplimentele pe care suntem nevoiți să le luăm într-un anumit context.
Microbiomul intestinal versus microbiota intestinală
După cum ai observat, microbiomul intestinal poate fi văzut ca un ecosistem complex, cu rol-cheie în sănătatea ta fizică și emoțională. Practic, e „centrul de comandă” care îți poate dicta starea de spirit din fiecare zi.
În termeni simpli, microbiomul intestinal conține microbiota intestinală, care nu e altceva decât flora intestinală, compusă din bacterii „bune” și „rele”, care cântăresc aproximativ 2 kg. Poate nu te-ai gândit niciodată, dar sănătatea ta digestivă și echilibrul florei intestinale depind în mod direct de diversitatea acestor bacterii. Totodată, este important ca acestea să coexiste, cu condiția ca balanța să încline în favoarea „bacteriilor bune”.
Mai mult, fiecare persoană în parte are o microbiotă unică, influențată de obiceiurile și alegerile alimentare pe care le face, nivelul de stres la care este expusă zi de zi, calitatea somnului și alți factori de mediu.
Beneficiile unui microbiom intestinal sănătos
În mod normal, asociem buna funcționare a sistemului digestiv cu echilibrul florei intestinale. Însă o floră intestinală diversă, în care „bacteriile bune” le depășesc ca număr pe cele „rele” îți poate susține organismul pe multiple planuri.
Printre beneficiile de care te poți bucura se regăsesc:
- Creșterea rezistenței organismului și protejarea acestuia în fața agenților patogeni.
- Redobândirea vitalității și energizarea organismului prin susținerea unui proces eficient de absorbție a nutrienților necesari, cât și prin descompunerea moleculelor mari din alimente precum legumele sau carnea.
- Întărirea sistemului imunitar prin dezvoltarea adaptabilității acestuia și rafinarea mecanismelor de răspuns în fața microorganismelor dăunătoare. Practic, flora intestinală ajută sistemul imunitar să învețe diferența dintre agenții patogeni și substanțele inofensive pentru corp. În plus, flora intestinală influențează echilibrul dintre inflamație și toleranță. Un dezechilibru al microbiotei intestinale poate declanșa reacții imune anormale, de la alergii până la boli autoimune sau inflamații cronice.
Știai că …
microbiota intestinală influențează în mod direct echilibrul emoțional? Obiceiurile alimentare nesănătoase pot în timp să-ți deregleze atât digestia, cât și stările emoționale, prin accentuarea unor stări de apatie și iritabilitate, sau pe un fond emoțional deja vulnerabil, să intensifice simptome caracteristice unor tulburări precum depresia sau anxietatea.
Altfel spus, microbiota intestinală, cunoscută și ca floră intestinală, și creierul comunică permanent prin ceea ce se numește axa intestin-creier. Această legătură conectează emoțiile și funcțiile cognitive ale creierului cu activitatea intestinului, prin intermediul nervilor, hormonilor și a altor semnale chimice din corp.
Gândește-te doar la perioadele stresante din viața ta și la impulsul comun de a te „regla” emoțional prin alimente dulci sau snackuri sărate, bogate în grăsimi. Poate că efectul de liniștire este instant, însă organismul tău cade pradă pe termen lung unor serii de dezechilibre pe care îți va fi dificil să le combați.
Factori de risc pentru dezechilibrul microbiomului intestinal?
Din punct de vedere medical, dezechilibrul florei intestinale se numește disbioză. Acest dezechilibru se creează atunci când varietatea bacteriilor din intestin este redusă, iar numărul bacteriilor „rele” este mai ridicat decât cele „bune”.
Disbioza are consecințe directe: digestia deficitară, cât și alte dereglări la nivelul organismului, de la slăbirea imunității până la dezechilibre hormonale, creșterea în greutate sau o piele cu aspect nesănătos.
Pentru a preveni instalarea disbiozei, este important să știi ce să eviți. Printre cei mai comuni factori de risc pe care merită să-i ai în vedere, se numără:
- perioadele suprasolicitante și stresante, în care sistemul tău nervos este constant în alertă
- consumul îndelungat de alimente ultra-procesate, dulciuri rafinate, îndulcitori artificiali sau produse pe bază de lactoză;
- dietele restrictive, urmate cu scopul de a slăbi vizibil și în timp record;
- consumul excesiv de alcool;
- activitatea fizică/sportivă practicată până la epuizare;
- menopauza care vine cu provocări specific feminine;
- excesul de antibiotice, care pot perturba echilibrul florei intestinale și al comunităților microbiene, scăzând capacitatea de luptă a organismului.
Redobândește-ți echilibrul intestinal cu alimentele potrivite
La polul opus disbiozei se află eubioza, adică acea stare de echilibru a florei intestinale la care tânjim cu toții. Vestea bună este că acest echilibru este 100% în controlul tău și îl poți instaura prin adoptarea unui regim alimentar sănătos, dublat de probioticele potrivite.
Dacă ar fi să le luăm pe rând, îți spunem că merita să incluzi pe lista de cumpărături și în dieta zilnică următoarele alimente sau ingrediente:
- castraveți murați;
- măsline negre sau verzi în saramură;
- kefir sau iaurturi slabe;
- oțet de mere;
- banane;
- usturoi;
- ceapă albă;
- praz;
- sparanghel;
- anghinare;
- kimchi;
- tempeh;
- avocado;
- fulgi de ovăz;
- semințe de chia;
- ulei de cocos.
Ca o regulă generală, pentru menținerea unui microbiom intestinal sănătos, este necesar ca alimentația ta să se bazeze pe fibre, surse naturale de probiotice și alimente bogate în grăsimi sănătoase, cu efect antiinflamator.
Susține-ți obiceiurile alimentare sănătoase cu probiotice atent alese
Pe lângă regimul alimentar, corpul tău are nevoie de puțin ajutor pentru o reglare completă a florei intestinale, iar acest sprijin vine sub forma probioticelor. După cum ai observat, antibioticele elimină infecțiile din organism, dar pot dăuna „bacteriilor bune” din intestin. De aceea, specialiștii recomandă suplimentarea cu probiotice în timpul sau după tratamentele pe bază de antibiotice, în scopul refacerii integrității florei intestinale și pentru prevenirea tulburărilor digestive.
Însă nu orice probiotic este recomandat. Efectele benefice apar doar când folosim tulpina potrivită în funcție de nevoile organismului nostru. În cazul curelor cu antibiotice, anumite tulpini de Lactobacillus pot fi mai eficiente decât altele în reechilibrarea microbiomului intestinal.
Pentru că alegerea corectă poate face diferența dintre un intestin protejat și unul vulnerabil, iată spre ce tulpini de probiotice să-ți îndrepți atenția:
- Lactobacillus rhamnosus: este probioticul cu cele mai multe beneficii demonstrate, datorită proprietății sale de a reduce semnificativ capacitatea de aderență a agenților patogeni la flora internă. Această tulpină are proprietăți antimicrobiene, de ajutor împotriva unui spectru larg de agenți patogeni, printre care E.coli, salmonella sau streptococul auriu.
- Lactobacillus Casei Rosell – 215: este o tulpină care previne diareea asociată administrării de antibiotice și este recunoscută pentru abilitatea sa de a produce acid lactic, ceea ce contribuie la reducerea pH-ului din sistemul digestiv, în scopul de a împiedica proliferarea bacteriilor dăunătoare
- Lactobacillus helveticus lafti: contribuie la modularea sistemului imunitar și tratarea mucoasei interne deteriorată de antibiotice.
- Lactobacillus plantarum: este responsabilă de procesele de fermentare, fiind una dintre tulpinile predominante în intestinul uman datorită rezistenței sale la mediul ostil din tractul gastrointestinal. Are un efect benefic asupra sindromului de colon iritabil, reducând durerile abdominale și îmbunătățind funcționarea tractului gastrointestinal.
- Bifidobacteriul Lactis HA-194: sprijină sănătatea microbiomului prin îmbunătățirea funcțiilor intestinului și oferă protecție împotriva unor agenți patogeni precum K. pneumoniae, E.coli și N.gonorrhoeae.
Un microbiom intestinal sănătos: de ce să alegi probioticele Ultrabiotique
Dacă ai urmat recent o cură cu antibiotice sau pur și simplu simți nevoia să-ți echilibrezi flora intestinală după răsfățuri culinare, probioticele din gama Ultrabiotique au fost create special pentru starea ta de bine și prevenția digestiei deficitare.
Gama de probiotice Ultrabiotique de la Vitavea este produsă în Franța de grupul Havea, cel mai mare producător european de suplimente alimentare naturale, și se remarcă prin standardele înalte de calitate și eficiență. Miza gamei este îmbinarea atentă și avizată a tulpinilor de probiotice în combinații care le potențează reciproc efectul.
Pentru a face față provocărilor zilnice, gama Ultrabiotique te susține cu o selecție de suplimente dedicate nevoilor tale:
- Ultrabiotique ATB: conține 20 de miliarde de fermenți lactici aparținând celor cinci tulpini principale de probiotice. Suplimentul se administrează ușor, în cure de 10 zile, fiind sub formă de capsule gastrorezistente la aciditatea gastrică și la sărurile biliare.
- Ultrabiotique Equilibre: este o formulă completă, în care se regăsesc cele mai bune tulpini de fermenți lactici pentru echilibrul microbiomului intestinal.
- Ultrabiotique Instant: conține 5 tulpini și 20 miliarde de culturi vii, fiind alegerea potrivită în cazul unei dereglări majore a microbiomului intestinal, manifestată prin diaree severă.
- Ultrabiotique Infantile: reprezintă formula special creată pentru copii de peste 3 ani, sub formă de plicuri, care se remarcă prin compoziția unică pentru imunitatea și echilibrul florei intestinale a micilor exploratori din familia ta – două tulpini de fermenți lactici și șase miliarde de culturi vii + vitaminele A și D3.
Nu uita! Înainte de a începe o cură cu probiotice, apelează la sfatul medicului curant și alege în funcție de sugestiile personalizate pe care ți le oferă!
Bucură-te de un microbiom sănătos chiar de la prima capsulă! Hai pe site-ul vegis.ro și află mai multe despre acțiunea complexă a probioticelor din gama Ultrabiotique!
Surse bibliografice:
- Medical News Today, medicalnewstoday.com
- National Library of Medicine (National Center of Biotechnology Information)
- https://pmc.ncbi.nlm.nih.gov/
- https://nutritionsource.hsph.harvard.edu/microbiome/
- https://www.healthline.com/health/10-gut-foods
- https://www.healthline.com/nutrition/8-health-benefits-of-probiotics
- https://my.clevelandclinic.org/health/treatments/14598-probiotics